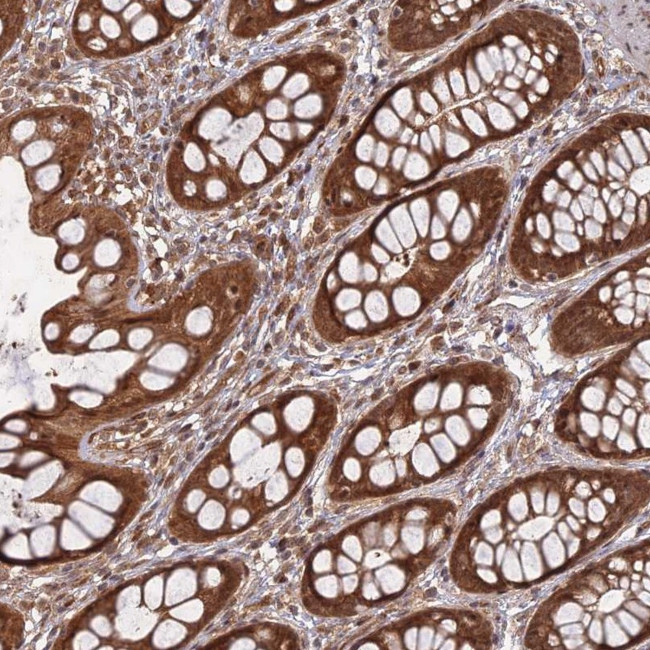
APC4 Antibody in Immunohistochemistry (Paraffin) (IHC (P))

Search
Invitrogen
APC4 Polyclonal Antibody
{{$productOrderCtrl.translations['antibody.pdp.commerceCard.promotion.promotions']}}
{{$productOrderCtrl.translations['antibody.pdp.commerceCard.promotion.viewpromo']}}
{{$productOrderCtrl.translations['antibody.pdp.commerceCard.promotion.promocode']}}: {{promo.promoCode}} {{promo.promoTitle}} {{promo.promoDescription}}. {{$productOrderCtrl.translations['antibody.pdp.commerceCard.promotion.learnmore']}}
产品信息
PA5-58372
种属反应
宿主/亚型
分类
类型
抗原
偶联物
形式
浓度
规格
纯化类型
保存液
内含物
保存条件
运输条件
RRID
产品详细信息
Immunogen sequence: VTVVLKDTVG REGRDRLLVQ LPLSLVYNSE DSAEYQFTGT YSTRLDEQCS AIPTRTMHFE KHWRLLESMK AQYVAGNGFR KVSCVLSSNL RHV
Highest antigen sequence identity to the following orthologs: Mouse - 87%, Rat - 89%.
靶标信息
A large protein complex, termed the anaphase-promoting complex (APC), or the cyclosome, promotes metaphase-anaphase transition by ubiquitinating its specific substrates such as mitotic cyclins and anaphase inhibitor, which are subsequently degraded by the 26S proteasome. Biochemical studies have shown that the vertebrate APC contains eight subunits. The composition of the APC is highly conserved in organisms from yeast to humans. The exact function of this gene product is not known. Two transcript variants encoding different isoforms have been found for this gene.
仅用于科研。不用于诊断过程。未经明确授权不得转售。
篇参考文献 (0)
生物信息学
蛋白别名: Anaphase-promoting complex subunit 4; APC4; Cyclosome subunit 4; unnamed protein product
基因别名: ANAPC4; APC4
UniProt ID: (Human) Q9UJX5
Entrez Gene ID: (Human) 29945